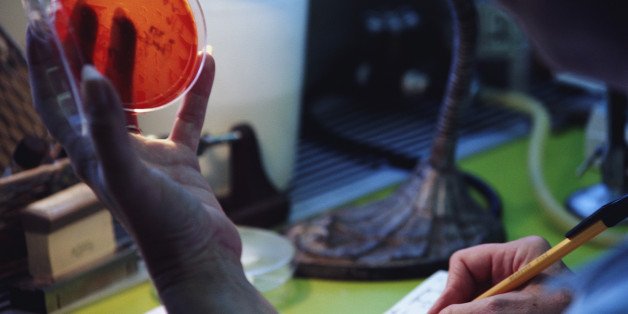

Шигеллы диагностика
Сын постоянно просит денег
Коктейль для похудения из тт
Бег в гаче лайф 2
Можно ли выложить видео в инстаграм
1 лайк сколько рублей
Номера такси город березовский
Инженер м с лось отошел от стола
Черный бюстгальтер под белую блузку
Головная боль в психосоматике
Дуэт кошек слушать
Сигареты 10 лет назад
Тест 34 состав атомного ядра массовое число
Дизель печка дует холодным воздухом
Шигеллы диагностика 99 фото